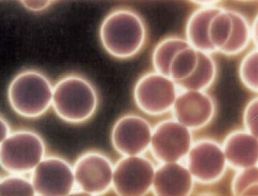

| . |
| . |
| FDA Disclaimer: The statements made within this website have not been evaluated by the Food and Drug Administration. These statements and the products of this company are not intended to diagnose, treat, cure, or prevent any disease. |
 |
| Purification and Enhancement ...the Healthier Water! |
| Volcanic Mineral Enhancement |
| Chemicals, Metals, Radionuclides |
| Bacteria, Virus and Drug Protection |
| Mountain Spring Quality Water on Demand Energy Stone Water Filter provides truly healthier mountain spring quality water. Naturally filtered water is provided without the use of reverse osmosis, distilled, or eletricity. With an elegantly simple, three cartridge system that begins with precise, virus-level purification, exceptionally clean water results as it passes through seven filtration stages. And unlike reverse osmosis and distilled water filters, the minerals such as calcium,. potassium and magnesium, that contribute to energy and an alkaline pH water are never removed from filtered water during purification and enhancement process. Five enhancement stages, include rare volcanic mineral stones, magnetite ore, ceramic. ring magnets and energy bio-ceramic, impart water with the structural, energetic and trace mineral components that give highly regarded mountain spring and deep well waters around the earth their clean, refreshing tastes, and physical and energetic properties. |
 |
| The NanoCeram-PAC electropositively-charged media cartridge, provides superior absortion. It protects against 99.999%+* of bacteria, and 99.97%+* of viruses, while also protecting users from harmful endocrine disruptors, drugs and hormones that have been found in many recycled municipal water supplies. It also retains fine colloidal particulates from. water, which can include pathogenic cysts, Giardia, Intestinalis, Legionella, Cryptosporidium, E-coli, Pseudomonas, Salmonella, Aspergillus, DNA, RNA, endotoxins, as well as, chlorine, VOCs, heavy metals, phospholipids, oil, oil emulsions, bad tastes, odors, and more. NanoCeram is of significant benefit when accounting for the past. occassional outbreaks of Hepatitis A and Norwalk virus.* See below for details of the benefits and advantages of. using NanoCeram filter technology. *https://www.ncbi.nlm.nih.gov/pubmed/10558930.. *https://www.cdc.gov/mmwr/preview/mmwrhtml/rr5009a1.htm *https://www.ncbi.nlm.nih.gov/pubmed/6286788 |
| Purification and Fluoride Reduction Cartridges Fluoride Reduction Cartridge - Removes Fluoride and radio-isotopes from. water which include Americium-241, cadmium , colbalt-57, 60, cesium-137, zinc-65 manganese-54 , yttrium-88 , iodine-131 , radon , radioactive metal componds, radio- nuclides; also VOCs, SOCs, and other contaminants. Removes heavy metals including fluoride, aluminum, arsenic III, arsenic V, cadmium,. chromium III, chromium IV, copper, iron, lead, manganese, mercury, nickel, silver, zinc, strontium, uranium, vanadium, bromine, selenium, hexavalent chromium. KDF-55 and Catalytic Carbon - Combine to remove heavy metals, chloramines, chlorine, hydrogen,.. iron, bad odors and tastes, hydrogen sulfide, chemicals; many more undesireables from tap water. Zeolite - Removes radio-nuclides, ammonia -- and removes, blocks or adsorbs algea, bacteria. cryptosporidium, nitrates, phosphates, iron, manganese, Giardia, cyst, nitrogen, certain organic hydrocarbons, and toxic cations such as silver, mercury, nickel, cobalt, arsenic. Coconut Shell Carbon - Removes chlorine, VOCs, pesticides, herbicides, THMs, radon, solvents,. MTBE, chemical compounds, and many other chemicals, contaminants and additives that are found in tap water. Serves to 'polish' water, removing bad tastes and odors. |
| . |
| Precise Nano-Level Purification Originally developed in partnership with NASA for the US Space Program, NanoCeram cartridge combines the benefits of pleated filters with virus level reduction. Change the NanoCeram cartridge at 18 months at the latest, or before, if it becomes saturated from heavy use. |
| . |
 |
| . |
| Multi-purpose cartridges* removes a wide range. of contaminants including, metals, chemicals, fluoride and radio-nuclides, chlorine, chloramines, VOCs, THMs, bad tastes. Cartridges should be replaced every 18 months for optimal performance. (pair). |
| *Performance and cartridge life will depend upon contaminant levels in individual water supplies. HIgher levels of contaminants may require earlier cartridge replacement. |
| . |
| . |
 |
 |
 |
| . |
| . |
 |
 |
 |
 |
 |
 |
 |
 |
| Magnetite and Ceramic Magnets nullify harmful energy frequencies of contaminants that have been imprinted on water from its prior contact with toxins and harmful chemicals.This energic cleansing results in a filtered water that is both physically and energetically clean. The magnetite and ring magnets also impart to water a. reduced structure that has a lower internal surface tension -- a quality that enhances the water's solubility -- it's ability to penetrate and dissolve foods and nutrients and hold an increase level of dissolved substances. The smaller molecular structure makes the water more. bio-available for enhanced hydration. The water is able better cross cell membranes, resulting in improved inner cellular hydration, and general hydration to cells, organs and tissues. Reduced structure water contains small, spherical mineral colloids -- tiny,. high-energy particles which carry a negative charge. The negatively charged water molecules cluster around the colloid, resulting in an organized symmetric (hexagonal shaped) water structure. Pi Energy Ceramic contributes to a lower ORP value, increased water energy and reduced water structure; |
| and provides far-infrared energy and negative hydrogen ions. Pi Energy Ceramic enhances metabolism and the body's natural healing process, and supports the body's immune system. Bakuhan-seki provides filtered water with energy, structure and mineral properties that contribute to a healthy and delicious-tasting mountain spring quality water. Bakuhan-seki elutes the important minerals silica, potassium, magnesium, calcium to filtered water. Bakuhan also imparts anti-bacterial and anti- fungal properties, contributes to a healthy alkaline water, and their combined energy, structural and mineral properties make for water of excellent and rare qualities. SGE Stone contributes superior far- infrared energy and trace minerals that provides many benefits.to the body's health in both general and specific ways. Various Japanese studies have shown the benefits of drinking water filtered through SGE Stone to include: Rejuvenating and preserving cellular energy. and vitality. Enhanced immune function, and accelerate. regenerative healing. Reduces undesirable odor. emissions, such as with feet and armpits. Emits healthy far-infrared. energy, creates healthy negative hydrogen ion antioxidants; promotes SOD and anti-inflammatory effect. Inhibits lipid peroxide formation.. Restores energy to dead tap water.. SGE Improves Blood Circulation. "We conduction an experiment on blood circulation after drinking SGE water, using an ultrasonic Doppler blood flow measuring device. We monitored blood circulation every 30 minutes for three hours after drinking 400ml (13 oz.) of SGE water. "In this experiment, blood circulation speed. increased as time elapsed. We conducted the same experiment with tap water for a control group, but there were no changes in b the blood circulation speed. The experiment showed that SGE water helps to improve blood circulation, one of the major factors factors to maintain human health, and heightens metabolic functions of the human body." -- Dr. Shoji Kubota, Dr. of Science, Chief Director of the Society of Water Design and Member, SGE Research Team |
 |
 |
 |
 |
| . |
| Bakuhan Stone Mineral Profile. Silicon dioxide (SiO2)* 71.23%.. Aluminum oxide (Al2O3) 14.21% Iron oxide (also Fe2O3) 3.23% Magnesium oxide (MgO ) 3.22% Calcium oxide (CaO) 3.18% Sodium oxide (Na2O) 1.88% Potassium oxide (K2O) 1.82% Titanium dioxide (TiO2) 0.36% Phosphoric pentoxide (P2O5) 0.22% Manganese oxide (MnO) 0.02% other mineral content 0.63% SGE Stone Mineral Profile Silicon dioxide (SiO2)* 67.4%. Aluminum oxide (Al2O3) 14.8% Iron (Fe2O3) 4.31% Sodium oxide (Na2O) 4.09% Calcium oxide (CaO) 3.41% Potassium oxide (K2O) 3.00% Magnesium oxide (MgO ) 1.93% Titanium dioxide (TiO2) 0.504% Phosphoric pentoxide (P2O5) 0.148% Fluorine (F) 0.128% Manganese oxide (MnO) 0.0924% Barium (BaO) 0.0750% Strontium (SrO) 0.0610% Sulfur trioxide (SO3) 0.0349% Zirconium dioxide (ZrO2) 0.0241% Chlorine (Cl) 0.0236% Chromium trioxide (Cr2O3) 0.0124% Rubidium oxide (Rb2O) 0.0110% Zinc oxide (ZnO) 0.0067% Additional micro minerals that are. found in Super Growth Energy Stone . Copper Vanadium Colbalt Germanium. Selenium Iron Iodine Boron Lithium Antimony Molybdenum Nickel Silver Lanthanum Lutetium Erbium *Silicates and other minerals are now known to perform vital structural and functional roles within cells and tissues, including the transport of small ions, minerals and electrolytes (i.e. hydrogen, sodium, calcium, magnesium). *Silica serves an important function in that it encapsulates hydrogen atoms and their hydrogen ion antioxidant properties, protecting them from the acids of the digestive system until they are transported and made available to the body at the cellular level. |
| 71.23% 14.21% 3.23% 3.22% 3.18% 1.88% 1.82% 0.36% 0.22% 0.02% 0.63% |
| 67.4% 14.8% 4.31% 4.09% 3.41% 3.00% 1.93% 0.504% 0.148% 0.128% 0.0924% 0.0750% 0.0610% 0.0349% 0.0241% 0.0236% 0.0124% 0.0110% 0.0067% |
| . |
| . |
| . |
| The Energy Stone Water Filter mineral cartridge addresses the very critical aspect of providing a complete -- mineral enhancement. Physically clean filtered water without natural mineral enhancement imparting structural, energetic and trace minerals qualities is simply not a complete water -- nor is it a fully healthy water. In this respect, the Energy Stone Water Filter dupicates in miniature, the manner in. which water is enhanced in nature -- contact and filtration with natural earth minerals. Volcanic Mineral Ehancement Cartridge: $349.00. |
| Understanding The NanoCeram-PAC Advantage |
| . |
| Hydration and Your Physical Well Being As a society, we are seriously under. hydrated. Although a new born baby is about 90% hydrated, a 65-year-old person may only be about 55% hydrated. Inner cellular hydration accounts for most of that difference. With increase in age, the internal water content of the cells of the body decreases by a dramatic degree -- about 40%. The proper level of hydration is critical in. regulating body temperature, maintaining a healthy alkaline level, while importantly, facilitating the flushing of acidic wastes by- products of digestion and other bodily functions from cells, organs and joints, etc. Proper hydration with good water assists the body in keeping these acidic wastes from accumulating and contributing to an acidic environment and the resulting failure of the body's organs and systems, leading to various degenerative diseases. The 70 Percent Solution A healthy body consists of about 70% water, a level that is absolutely essential for the hydrolytic (water-dependent chemical reactions) role of water in maintaining the healthy functioning of the body's metabolic many systems. As a hydraulic system, the body requires. water to perform the many 'hydroelectric' functions at the cellular level -- from the breaking down of proteins and nutrients into amino acids, to the functioning as the 'glue' that bonds cellular membranes together, thus performing a vital role in the metabolism of energy as well as a variety of vital metabolic functions. Water also ionizes salts, which provides the electrolyte environment for. electrochemical conduction of nerve impulses, leading to more effective nerve firing as the polarity of membranes is increased. Water Equals Energy in the Body When the body moves, the water in the body moves. When the water in the body moves, energy is produced, like a biochemical hydroelectric generator. This energy assists the burning of fat stored in the body by boosting the metabolism and energy of the body that helps the muscles to contract harder during exercise or training. Water also works as a regulator of body energy through osmotic balancing. Energy is available from three major sources in the body: ATP (adenosine. triphosphate), GTP (guanosine triphosphate), and Calcium dumps (endoplatic reticulum). With added water intake before exercise activies, ATP production can be increased. This is important as ATP is an important requirement during the increased muscular contractions that come with exercising. The ATP production increased during exercise has the added benefit of providing greater muscle contraction. Water and Efficient Brain Function Consisting of just 2% of overall body weight, the brain is 75-85% water and requires 20% of the blood supply. The brain can only tolerate a 1% loss of water. Water gives the brain power for thinking by assisting the function of neurotransmitters. Serotonin and melatonin are produced only when adequate brain hydration is present. Water increases the work efficiency of the brain; attention span is lengthened and normal sleep rhythms are restored. Memory loss can be prevented as we age, by adequate water intake. Water and Electrolyte Balance Electrolytes are salts that conduct electricity and are found in the body fluid, tissue, and blood. They are specifically termed ions, and exist in the body as positive and negative ions. Water is very important in maintaining the electrolyte. balance within the body. Electrolytes are charged ions which must be kept at certain levels to maintain the proper amount of water in our cells. Major electrolytes (ions) in humans are: sodium (Na+) potassium (K+) chloride (Cl-). calcium (Ca2+) sulfate (SO42-) magnesium (Mg2+) bicarbonate (HCO3-) phosphate (PO42-) Electrolyte balance is important for the coordination of muscle, proper. function of the heart, the absorption and excretion of fluid, concentration and nerve function. To maintain proper electrolytes levels, water flows in and out of the cell to insure that these ions remain in balance. Hydrate for Healthy Skin A square inch of skin contains 9.5 million cells, 19 yards of blood vessels, 78 yards of nerves, 95 oil glands, and 650 sweat glands. Our skin feels soft and supple when it is at least 10% hydrated. When the skin's water content is between 20% and 35%, it reflects the healthiest texture and appearance. Our skin is moisturized from the water we drink, and the oil (sebum) that our skin naturally produces. These work in combination on the surface of the skin to form an 'acid mantle' that keeps the skin soft and supple by retaining more water in the deeper layers of the skin, the proper hydration of which contributes to health and beauty! Hydration and Kidney Function The kidneys regulate the amount of water in our bodies, filter blood and excrete waste products in the urine, and also play a significant role in controlling blood pressure. If the kidneys suffer from dehydration it can lead to high blood pressure, which can contribute to cardio- vascular disease, heart attacks and strokes. Kidney stones are formed when there is a high level of. calcium oxalate, or uric acid in the urine; a lack of citrate in the urine; or insufficient water in the kidneys to dissolve waste products. The kidneys must maintain an adequate amount of water in the body to remove waste products. If dehydration occurs, high levels of substances that do not dissolve. completely contribute to the build-up of bacteria and proteins can cause kidney stones to form. Dehydration can lead to kidney damage and loss of kidney function. Symptoms of Serious Dehydration When the body is dehydrated and has no stored water to draw on, it adapts to this shortage of water so that vital bodily functions are preserved until water is supplied to the body. Histamines becomes a temporary substitute for water by releasing energy to some extremely essential body functions. The body then adapts to this false information that water is not available, resulting in a continued failure to drink water. Prolonged dehydration results in proteins and enzymes. becoming inefficient, and eventually, the cells cease to function. When the body is deficient in water, these cells wrinkle like prunes and cannot function efficiently (see photos to the left). Feeling tired, sluggish, poor concentration, apathy, fatigue, dry skin, rashes, coordination problems, mood swings, pain, swelling and edema are all symptoms of dehydration. Water for Back and Joint Lubrication Water lubricates our joints. The cartilage tissues found at the ends of long bones and between the vertebrae of the spine hold a lot of water. The water volume that is stored in our spinal disc core supports 75% of the upper body weight. The other 25% is supported the by fibrous materials around the discs. When cartilage is well hydrated, the opposing surfaces glide freely. This minimizes friction and any resulting damage. The spinal joints are dependent on different hydraulic properties of water. which is stored in the disc core. Back pain is frequently alleviated with hydration. Rheumatoid joint pain frequently decreases with increased water intake and flexing exercises to bring more circulation to the joints. |
 |
 |
 |
 |
 |
| Properly hydrated blood cells have a negative charge to the membrane, float freely, and are individually able to absorb water, nutrients and oxygen. |
|
| Blood cells at only about 30% hydrated coagulate, making it difficult for the cells to adsorb water, nutrients and oxygen, and flush acidic wastes that build up in the cells, thus creating an ideal environment for the onset of degenerative diseases. |
 |
| . |
| . |
| NanoCeram-PAC represents a paradigm shift in carbon filtration and builds on the break- through technology found in NanoCeram media by combining the benefits of sub-micron particulate filtration with exceptional chemical removal performance that significantly outperforms carbon block and Granular Activated Carbon (GAC) filter cartridges. Fine eight-micron activated carbon powder is held within the structure by electro-adhesive. forces, without adhesives, glues or starches that would bind or possibly deactivate the carbon. This allows NanoCeram-PAC to offer a much greater external surface area resulting in much more rapid adsorption of soluble contaminants. The electro-adhesive principle means a NanoCeram-PAC filter offers up to.. 40% more effective surface area compared to ordinary carbon filters of the same size. Greater surface area results in much more rapid and effective adsorption of soluble contaminants. NanoCeram-PAC offers performance improvements up to 800% greater over traditional carbon filters. Contaminants removed include chlorine, iodine or soluble organics that may. be highly toxic or cause unpleasant taste and odor. NanoCeram-PAC is also capable of retaining bacteria, virus and colloidal particles with efficiency that is unsurpassed in performance as compared to a depth media, a microporous membrane or even an ultraporous membrane. NanoCeram-PAC Performance Effective between 5-9 pH and in the presence of 30 g/L of NaCl, simulating seawater Turbidity (sediment) reduction maintained below. 0.01 NTU until terminal pressure drop (35 psi). Retained >6 LRV (99.999%) of bacteria (E coli). at a flow rate of 2 gpm*. Retained >3 LRV (99.9%) of virus (MS2) at a. flow rate of 2 gpm* . Removes both soluble and insoluble total organic. carbon (TOC's) Retains soluble organics (VOCs, toxic organics). and residual chlorine with high efficiency. For drinking water applications, the entire line of standard-sized NanoCeram-PAC filter. cartridges have been certified to the NSF/ANSI Std. 53 for Material Safety only. Further testing by the Water Quality Association determined that these filter cartridges reduce Cysts (parasites) by at least 99.98% at a flow rate of 2 gpm.* Other key application for NanoCeram technology are: chromatography, Filtration of DNA. RNA and endotoxins, sterilization of pharmaceuticals and medical serums, production of potable water, medical and dental offices, collector for biological warfare detectors. * Energy Stone Water Filer has a flow rate between .5 and .75 gpm. This longer contact time of the filtered water with the NanoCeram-PAC media may deliver a more enhanced effeectiveness of contaminant removal as compared with a 2 gpm flow rate. NanoCeram Filtration Advantages and Benefits Originally developed in partnership with NASA for the US Space Program, NanoCeram water filter cartridge combines the traditional benefits of pleated filters with virus level reduction with a nano material breakthrough that gives rise to a new class sub-micron filtration technology with outstanding contaminant removal performance. Virtually all contaminants in the sub-micron range. such as bacteria, viruses and colloidal particles, are electro-negative in water. They are naturally attracted to a positive electro force, similar to iron filings' attraction to a magnet. The physics applying at the nano scale means. NanoCeram fibers possess a powerful electro- positive force that easily attracts sub-micron contaminants. In one square meter of Nano- Ceram filter media there is in excess of 42,000 square meters (45,931 square yards) of active surface area. Standard water filters remove contaminants. based on the physical pore size of the contaminant and the media used to capture it. A NanoCeram water filter, composed of natural cellulose and microglass fibers creating a 2-3 micron pore size, works on similar principle but with one key difference. The fibers in a NanoCeram water filter are coated with trillions of nano fibers only 0.002 microns in diameter. These fibers are barely twice the size of a single water molecule and many times smaller than the virus- level contaminants they target for removal. The principal application of NanoCeram. filter material is based on their ability to remove bacteria, viruses and fine colloidal particulates from water. The use of Nano- Ceram is of significant benefit when taking into account that Hepatitis A and Norwalk virus outbreaks* have occurred on occasions. Recent studies have shown that viruses can percolate far further underground than bacteria and can contaminate ground water supplies as a result. Additionally, as the use recycled 'grey' and sewage water increases, NanoCeram filtration will play an important role in protecting consumers from harmful endocrine disruptors, drugs and hormones that have been found in recycled water supplies*. The NanoCeram-PAC filter cartridge is capable. of retaining 99.9%+ to 99.999%+ of micro- organisms (such as viruses, bacteria, protozoa which can include Cryptosporidium, Giardia Intestinalis, Legionella, Pseudomonas, Salmonella, E-coli, Mycobacteria, Aspergillus), endotoxins and DNA, as well as cell debris, proteins, colloids, natural organic matter, lipids, phospholipids, amino acids, oil, oil emulsions, all at flow rates hundreds of times greater than virus-rated ultra-filtration membranes. And water turbidity coming through the NanoCeram media typically remains below 0.01 NTU (nephelometric turbidity unit) even when tested at 250 NTU, until the filter cartridge is exhausted. *https://www.ncbi.nlm.nih.gov/pubmed/1673747. *https://www.ncbi.nlm.nih.gov/pmc/articles/PMC1645986 |
 |
 |
 |
 |
 |
 |
| Strong electromagnetic forces hold the carbon powder in place so tightly they cannot be removed without destroying the cartridge. |
 |
 |
 |